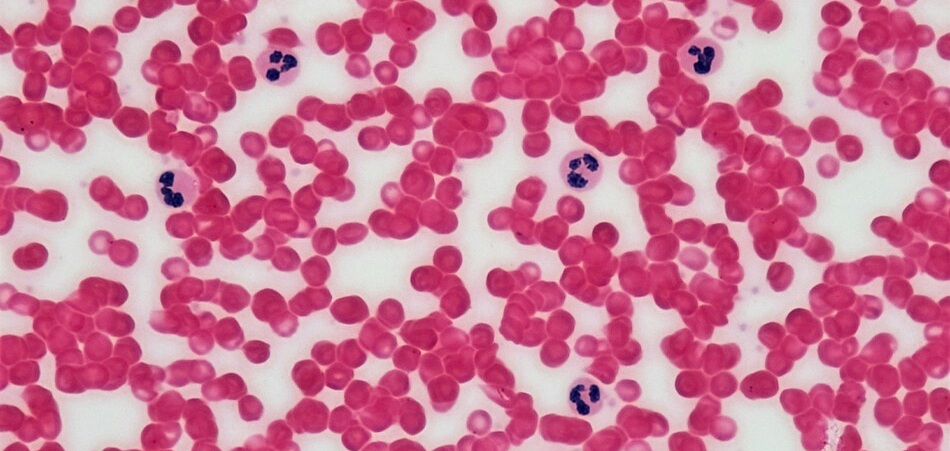
globulos rojos

La mayoría de los microplásticos provienen de la degradación de otros plásticos. Es decir, envases grandes como botellas o bolsas, con el tiempo, se van desgastando y liberan pequeñas partículas de plástico que pueden acabar entrando en nuestro organismo.
Tipos de microplásticos
Los microplásticos no son todos iguales. De hecho, se pueden clasificar principalmente según cómo se originan:
Primarios
Son aquellos que ya se fabrican directamente en tamaño pequeño, es decir, no provienen de la degradación de otros plásticos. Se crean para usos concretos en la industria.

Ejemplos:
- microesferas utilizadas (sobre todo en el pasado) en cosméticos exfoliantes
- partículas presentes en algunos productos de limpieza
- pellets industriales (materia prima para fabricar plástico)
Secundarios
Son los más comunes. Se generan a partir de la fragmentación de plásticos más grandes (como las botellas de plástico de uso cotidiano).
Este proceso ocurre por:
- exposición al sol (radiación UV)
- desgaste mecánico (rozamiento)
- acción del agua, el viento o el uso diario

Ejemplos:
- botellas de plástico
- bolsas
- envases
- fibras sintéticas de la ropa
Este tipo representa la mayor parte de los microplásticos que encontramos en el medio ambiente.
¿De dónde provienen y cómo se forman los microplásticos?
La mayoría de los microplásticos no se crean directamente, sino que provienen de la degradación de plásticos más grandes que usamos en el día a día.
Cuando un objeto de plástico, como una botella o una bolsa, se expone al entorno, no desaparece como otros materiales. En lugar de eso, empieza a deteriorarse poco a poco. Uno de los factores que más influye en este proceso es el sol. La radiación ultravioleta va dañando el plástico, haciendo que pierda resistencia y se vuelva más frágil.
Con el paso del tiempo, ese plástico empieza a agrietarse y a romperse en trozos cada vez más pequeños. A esto se suman otros factores como el viento, el agua o el propio uso. Por ejemplo, en el mar, el movimiento de las olas y el contacto con arena y otros materiales hace que los plásticos se desgasten aún más rápido. En tierra, el simple hecho de manipularlos o que rocen con otras superficies también contribuye a que se fragmenten.
El resultado es que ese objeto que antes era una botella o un envase acaba convertido en partículas muy pequeñas. Primero en fragmentos visibles, luego en trozos milimétricos y, finalmente, en microplásticos que ya no podemos ver a simple vista.
Además, hay fuentes que muchas veces pasan desapercibidas. Por ejemplo, la ropa sintética. Cada vez que lavamos en la lavadora prendas como el poliéster o el nylon, se liberan pequeñas fibras de plástico que acaban en el agua. Lo mismo ocurre con los neumáticos: el roce con el asfalto genera partículas microscópicas que se dispersan en el ambiente.
En resumen, los microplásticos no aparecen de la nada. Son el resultado de cómo los plásticos que utilizamos a diario se van rompiendo poco a poco, sin llegar a desaparecer, hasta convertirse en partículas muy pequeñas que terminan estando en todas partes.
¿Dónde se encuentran los microplásticos?
Una vez que los plásticos se han fragmentado en partículas tan pequeñas, el problema es que ya no se quedan en un solo sitio. Los microplásticos se dispersan fácilmente y terminan estando prácticamente en todas partes.
Hoy en día se han detectado microplásticos en el agua que bebemos, en los alimentos que consumimos e incluso en el aire que respiramos. Esto hace que la exposición no dependa de una sola fuente, sino de muchas pequeñas situaciones del día a día.
En el agua (embotellada y del grifo)
En el caso del agua, se han encontrado tanto en agua embotellada como en agua del grifo. Esto no significa que una sea necesariamente “segura” y la otra no, sino que los microplásticos están tan extendidos que pueden aparecer en ambos casos.
En los alimentos
También están presentes en los alimentos. Se han detectado en productos como pescado, marisco, sal o incluso en alimentos procesados. Esto ocurre porque los microplásticos acaban en el entorno natural y, a partir de ahí, entran en la cadena alimentaria.
En el aire y el ambiente
Otro punto importante es el aire. Aunque mucha gente no lo tiene en cuenta, los microplásticos también forman parte del polvo ambiental, especialmente en espacios interiores. Esto hace que no solo los ingiramos, sino que también podamos inhalarlos sin darnos cuenta.
¿Cómo entran los microplásticos en el cuerpo humano?
Principalmente los asimilamos a través de lo que bebemos y comemos. La mayoría de los microplásticos que se generan acaban entrando en nuestro organismo a través de la bebida y los alimentos. Muchos de ellos los eliminamos de forma natural a través de las heces y la orina, pero los más pequeños pueden llegar a atravesar el tubo digestivo y pasar a la sangre.
Los microplásticos que asimilamos a través del aire proceden principalmente de textiles sintéticos, de espacios cerrados sin ventilar, muebles u otros materiales también sintéticos.
Una vez dentro de nuestro organismo, no se conoce con exactitud el comportamiento de los microplásticos, ya que no existen estudios concluyentes que demuestren que sean dañinos o perjudiciales. Sin embargo, esto no significa que no puedan serlo.
¿Se acumulan los microplásticos en el organismo?
Actualmente, lo que sí se sabe es que los microplásticos de mayor tamaño son eliminados por nuestro propio cuerpo. No se puede afirmar con seguridad que los microplásticos se acumulen en el organismo.
Sí existen estudios que han detectado diminutas partículas de plástico en tejidos y en sangre, pero no hay evidencia de que lleguen a acumularse de forma significativa.
En el caso de los nanoplásticos, al ser aún más pequeños, existe la posibilidad de que interactúen a nivel celular, aunque este aspecto todavía se encuentra en investigación.
Efectos de los microplásticos en el cuerpo humano
Los estudios realizados en laboratorio, principalmente con células y animales, indican que los microplásticos podrían generar inflamación, estrés oxidativo y ciertos daños a nivel celular. También se ha planteado la posibilidad de que actúen como vehículos de otras sustancias químicas, ya que pueden transportar contaminantes adheridos a su superficie.
Es importante entender que estos efectos observados no se pueden trasladar directamente al organismo humano. A día de hoy, no se ha podido demostrar que los microplásticos estén generando enfermedades.
¿Cómo eliminar los microplásticos del organismo?
A día de hoy, no existe un método específico ni demostrado científicamente para eliminar los microplásticos del organismo de forma directa.
Lo que sí se sabe es que el propio cuerpo es capaz de eliminar parte de estas partículas de manera natural, principalmente a través de las heces y la orina. Este proceso ocurre sobre todo con los microplásticos de mayor tamaño, que no llegan a ser absorbidos por el organismo.
En el caso de las partículas más pequeñas, como los nanoplásticos, todavía no se conoce con exactitud cómo se comportan dentro del cuerpo ni si pueden eliminarse con la misma facilidad. Este es un campo que todavía está en investigación.
Es importante tener cuidado con ciertos mensajes que circulan sobre “eliminar microplásticos” mediante dietas, suplementos o métodos detox, ya que actualmente no existe evidencia científica que respalde estas afirmaciones.
En lugar de centrarse en eliminarlos, la recomendación más realista es reducir la exposición en el día a día, ya que es prácticamente imposible evitar el contacto con microplásticos por completo.
Cómo reducir la exposición a los microplásticos

Aunque es prácticamente imposible evitar los microplásticos por completo, sí se pueden reducir bastante en el día a día con algunos hábitos sencillos.
Uno de los más importantes es evitar calentar comida en recipientes de plástico. Cuando el plástico se expone al calor, puede degradarse más fácilmente y liberar partículas. Siempre que sea posible, es mejor utilizar recipientes de vidrio o acero inoxidable.
También es recomendable reducir el uso de botellas y envases de plástico, especialmente para bebidas. Optar por botellas reutilizables de materiales como vidrio o acero puede ayudar a disminuir la exposición.
Las prendas sintéticas, como el poliéster o el nylon, liberan microfibras en cada lavado. Usar programas de lavado suaves, evitar lavados innecesarios o utilizar bolsas especiales para microfibras puede marcar la diferencia.
La ventilación del hogar también influye. Muchos microplásticos se encuentran en el polvo de interiores, por lo que ventilar la casa con frecuencia y mantener una limpieza regular ayuda a reducir su acumulación en el aire.
En cuanto al agua del grifo, utilizar sistemas de filtrado puede reducir la cantidad de partículas presentes, aunque no todos los filtros son igual de efectivos.
Reducir el consumo de productos muy procesados y priorizar alimentos frescos también puede ayudar, ya que los procesos industriales y el envasado aumentan las posibilidades de exposición.
Filtros para eliminar microplásticos del agua
Los filtros básicos, como las jarras de agua que se llenan con agua del grifo, solo eliminan las partículas más grandes. Sin embargo, los filtros más avanzados, como los de ósmosis inversa, pueden eliminar hasta el 99 % de los microplásticos presentes en el agua.
¿Son peligrosos los microplásticos para la salud?
No existen, por el momento, pruebas concluyentes de que los microplásticos puedan dañar seriamente la salud a corto plazo.
Sí es cierto que algunos estudios, realizados principalmente en laboratorio con células y animales, han observado posibles efectos como inflamación, estrés oxidativo o daños a nivel celular. Sin embargo, estos resultados no se pueden trasladar directamente a lo que ocurre en el cuerpo humano en condiciones reales.
Además, hay que tener en cuenta que la exposición diaria a microplásticos es relativamente baja en comparación con las cantidades que se utilizan en muchos de estos estudios, lo que dificulta establecer una relación clara entre causa y efecto.
Referencias científicas
Presencia de microplásticos en el cuerpo humano
- Ragusa, A. et al. (2021). Plasticenta: First evidence of microplastics in human placenta. Environment International.
https://www.sciencedirect.com/science/article/pii/S0160412020322297 - Liu, S. et al. (2024). Microplastics in human placenta, cord blood, and meconium.
https://pmc.ncbi.nlm.nih.gov/articles/PMC11679465/ - Amato-Lourenço, L. F. et al. (2024). Microplastics in human organs: A review.
https://pmc.ncbi.nlm.nih.gov/articles/PMC11342020/
Vías de entrada en el organismo
- Cox, K. D. et al. (2019). Human Consumption of Microplastics. Environmental Science & Technology.
https://pubs.acs.org/doi/10.1021/acs.est.9b01517 - Prata, J. C. (2018). Airborne microplastics: Consequences to human health? Environmental Pollution.
https://www.sciencedirect.com/science/article/pii/S0269749118302188
Posibles efectos en laboratorio
- Yong, C. Q. Y. et al. (2020). Toxicity of microplastics and nanoplastics in mammalian systems. International Journal of Environmental Research and Public Health.
https://www.mdpi.com/1660-4601/17/5/1509 - Campanale, C. et al. (2020). A detailed review study on potential effects of microplastics and additives on human health. International Journal of Environmental Research and Public Health.
https://www.mdpi.com/1660-4601/17/4/1212
Incertidumbre científica actual
- World Health Organization (WHO) (2019). Microplastics in drinking-water.
https://www.who.int/publications/i/item/9789241516198 - European Food Safety Authority (EFSA) (2021). Presence of microplastics and nanoplastics in food.
https://www.efsa.europa.eu/en/news/microplastics-european-parliament-requests-scientific-advice-efsa
Sobre el autor
Para mí, ayudar a las personas no es solo una cuestión profesional. Me encanta desarrollar los lazos personales con mis clientes. Creo que eso es el ingrediente fundamental de mi éxito.
Una persona motivada y apoyada es capaz de conseguir cualquier objetivo que se proponga. Llevo más de 10 años de recorrido. Por ellos, he desarrollado una plataforma virtual que me ayude a estar en contacto con todos, para poder ver su progreso y realizar un seguimiento personalizado.